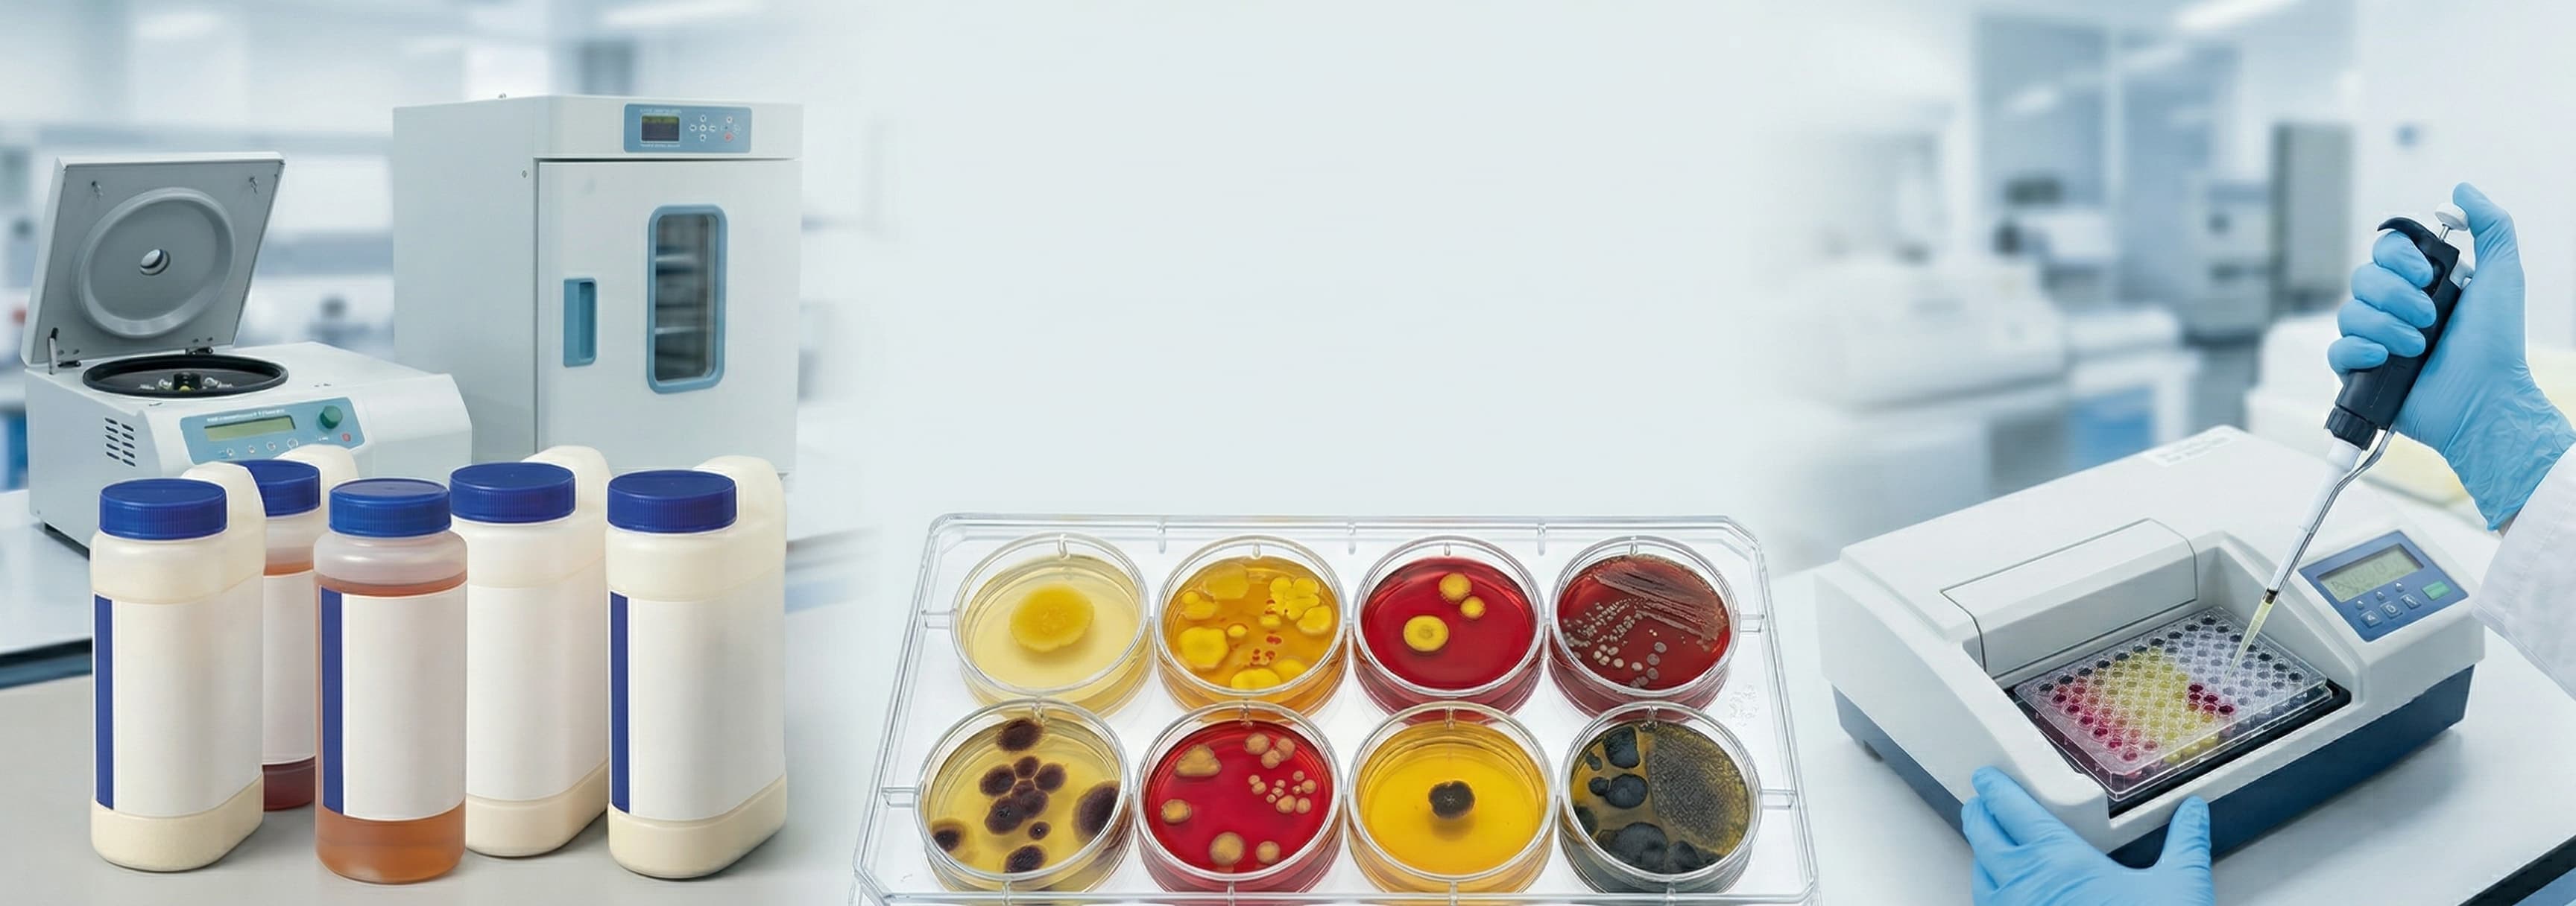
Môi Trường Nuôi Cấy Có Bổ Sung Máu
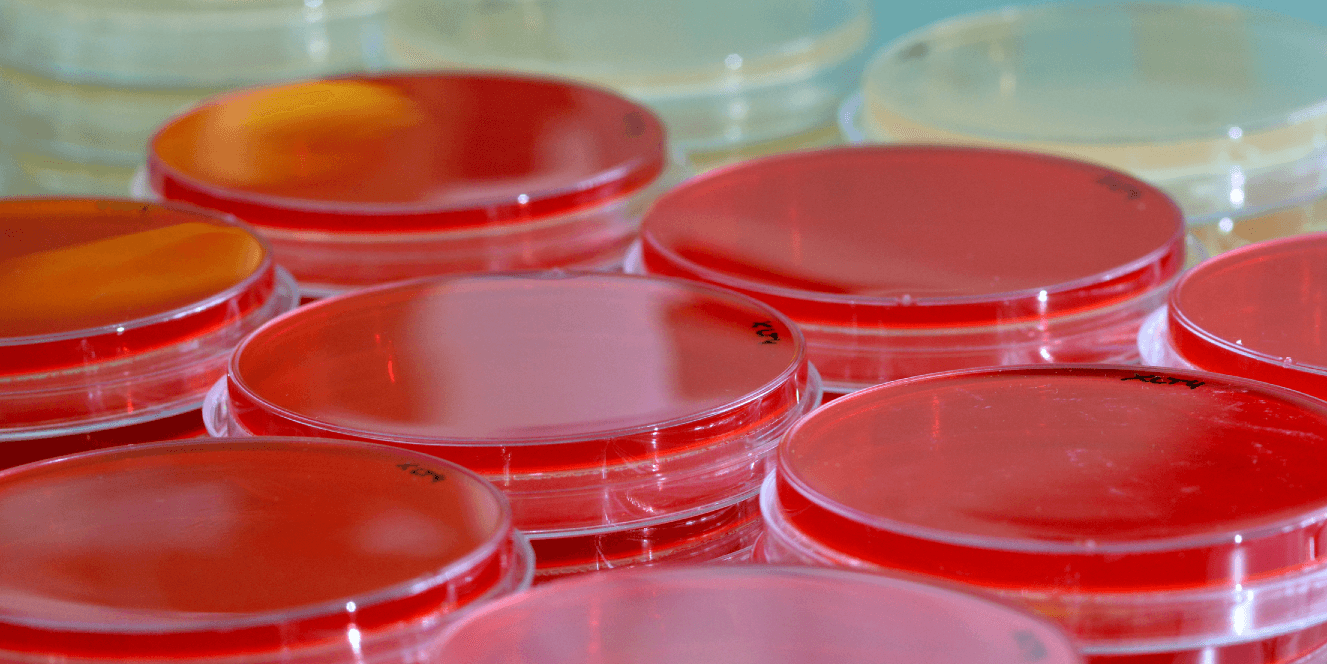
Hình Banner
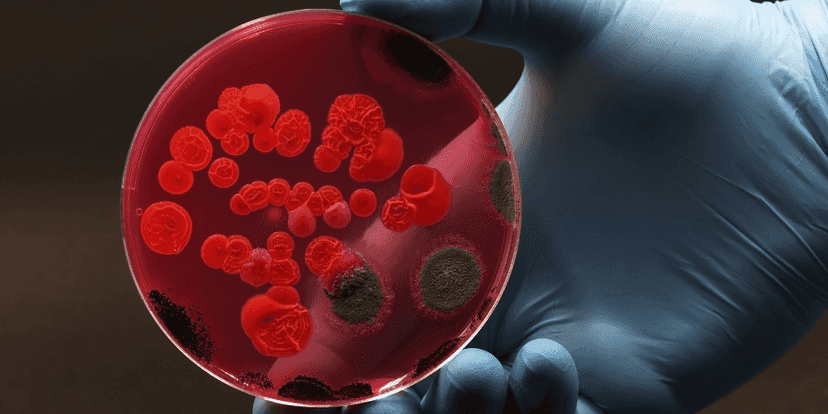
blur-mobile

Đang tải...
Đang tải...
Máu cừu được lấy vô trùng và được tách sợi tan huyết để tạo ra sản phẩm máu cừu tốt nhất dùng trong pha chế môi trường vi sinh.
Columbia Agar +5% Sheep Blood là môi trường nuôi cấy phổ rộng được đề xuất sử dụng để nuôi cấy phân lập hầu hết các loại vi sinh vật đáp ứng yêu cầu dinh dưỡng nhằm có thể nâng cao hiệu năng thu được khuẩn lạc các vi sinh vật tối đa mà không ảnh hưởng tới phản hứng heamolytic (tan máu) của chúng…..